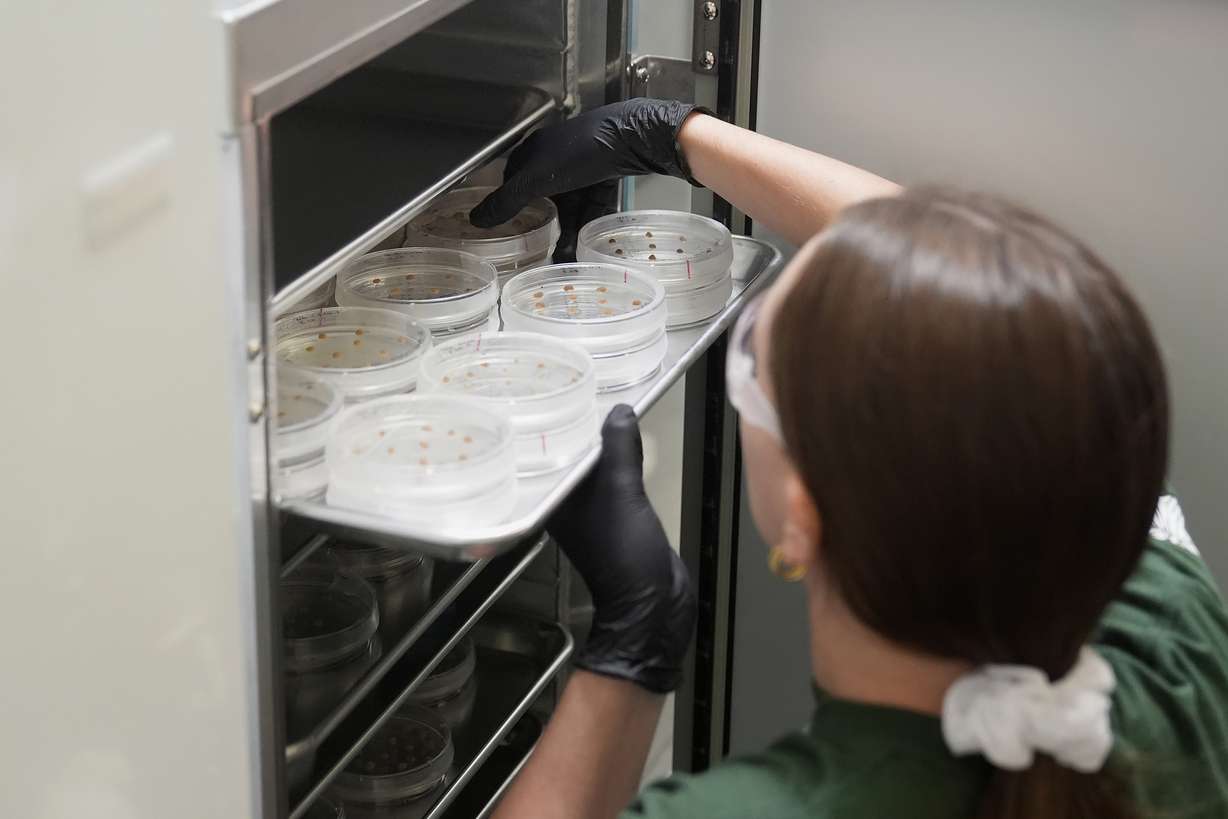
California Cultured lab technician Aubrey McKeand works on cell cultures in the company's lab in West Sacramento, Calif., Aug. 28.

Estimated read time: 5-6 minutes
This archived news story is available only for your personal, non-commercial use. Information in the story may be outdated or superseded by additional information. Reading or replaying the story in its archived form does not constitute a republication of the story.
WEST SACRAMENTO, Calif. — Climate change is stressing rainforests where the highly sensitive cocoa bean grows, but chocolate lovers need not despair, say companies that are researching other ways to grow cocoa or develop cocoa substitutes.
Scientists and entrepreneurs are working on ways to make more cocoa that stretch well beyond the tropics, from Northern California to Israel.
California Cultured, a plant cell culture company, is growing cocoa from cell cultures at a facility in West Sacramento, California, with plans to start selling its products next year. It puts cocoa bean cells in a vat with sugar water so they reproduce quickly and reach maturity in a week rather than the six to eight months a traditional harvest takes, said Alan Perlstein, the company's chief executive. The process also no longer requires as much water or arduous labor.
"We see just the demand of chocolate monstrously outstripping what is going to be available," Perlstein said. "There's really no other way that we see that the world could significantly increase the supply of cocoa or still keep it at affordable levels without extensive either environmental degradation or some significant other cost."
Cocoa trees grow about 20 degrees north and south of the equator in regions with warm weather and abundant rain, including West Africa and South America. Climate change is expected to dry out the land under the additional heat. So scientists, entrepreneurs and chocolate-lovers are coming up with ways to grow cocoa and make the crop more resilient and more resistant to pests — as well as craft chocolatey-tasting cocoa alternatives to meet demand.
The market for chocolate is massive with sales in the United States surpassing $25 billion in 2023, according to the National Confectioners Association. Many entrepreneurs are betting on demand growing faster than the supply of cocoa. Companies are looking at either bolstering the supply with cell-based cocoa or offering alternatives made from products ranging from oats to carob that are roasted and flavored to produce a chocolatey taste for chips or filling.
We see just the demand of chocolate monstrously outstripping what is going to be available.
–Alan Perlstein, California Cultured
The price of cocoa soared earlier this year because of demand and troubles with the crop in West Africa due to plant disease and changes in weather. The region produces the bulk of the world's cocoa.
"All of this contributes to a potential instability in supply, so it is attractive to these lab-grown or cocoa substitute companies to think of ways to replace that ingredient that we know of as chocolatey-flavored," said Carla D. Martin, executive director of the Fine Cacao and Chocolate Institute and a lecturer in African and African American Studies at Harvard University.
The innovation is largely driven by demand for chocolate in the U.S. and Europe, Martin said. While three-quarters of the world's cocoa is grown in West and Central Africa, only 4% is consumed there, she said.
The push to produce cocoa indoors in the U.S. comes after other products, such as chicken meat, have already been grown in labs. It also comes as supermarket shelves fill with evolving snack options — something that developers of cocoa alternatives say shows people are ready to try what looks and tastes like a chocolate chip cookie even if the chip contains a cocoa substitute.

They said they also are hoping to tap into rising consciousness among consumers about where their food comes from and what it takes to grow it, particularly the use of child labor in the cocoa industry.
Planet A Foods in Planegg, Germany, contends the taste of mass market chocolate is derived largely from the fermentation and roasting in making it, not the cocoa bean itself. The company's founders tested out ingredients ranging from olives to seaweed and settled on a mix of oats and sunflower seeds as the best tasting chocolate alternative, said Jessica Karch, a company spokesperson. They called it "ChoViva" and it can be subbed into baked goods, she said.
"The idea is not to replace the high quality, 80% dark chocolate, but really to have a lot of different products in the mass market," Karch said.
Yet while some are seeking to create alternative cocoa sources and substitutes, others are trying to bolster the supply of cocoa where it naturally grows. Mars, which makes M&Ms and Snickers, has a research facility at University of California, Davis aimed at making cocoa plants more resilient, said Joanna Hwu, the company's senior director of cocoa plant science. The facility hosts a living collection of cocoa trees so scientists can study what makes them disease-resistant to help farmers in producing countries and ensure a stable supply of beans.
"We see it as an opportunity, and our responsibility," Hwu said.
In Israel, efforts to expand the supply of cocoa are also under way. Celleste Bio is taking cocoa bean cells and growing them indoors to produce cocoa powder and cocoa butter, said co-founder Hanne Volpin. In a few years, the company expects to be able to produce cocoa regardless of the impact of climate change and disease — an effort that has drawn interest from Mondelez, the maker of Cadbury chocolate.
"We only have a small field, but eventually, we will have a farm of bioreactors," Volpin said.
That's similar to the effort under way at California Cultured, which plans to seek permission from the U.S. Food and Drug Administration to call its product chocolate because, according to Perlstein, that's what it is.
It might wind up being called brewery chocolate, or local chocolate, but chocolate no less, he said, because it's genetically identical though not harvested from a tree.
"We basically see that we're growing cocoa — just in a different way," Perlstein said.







